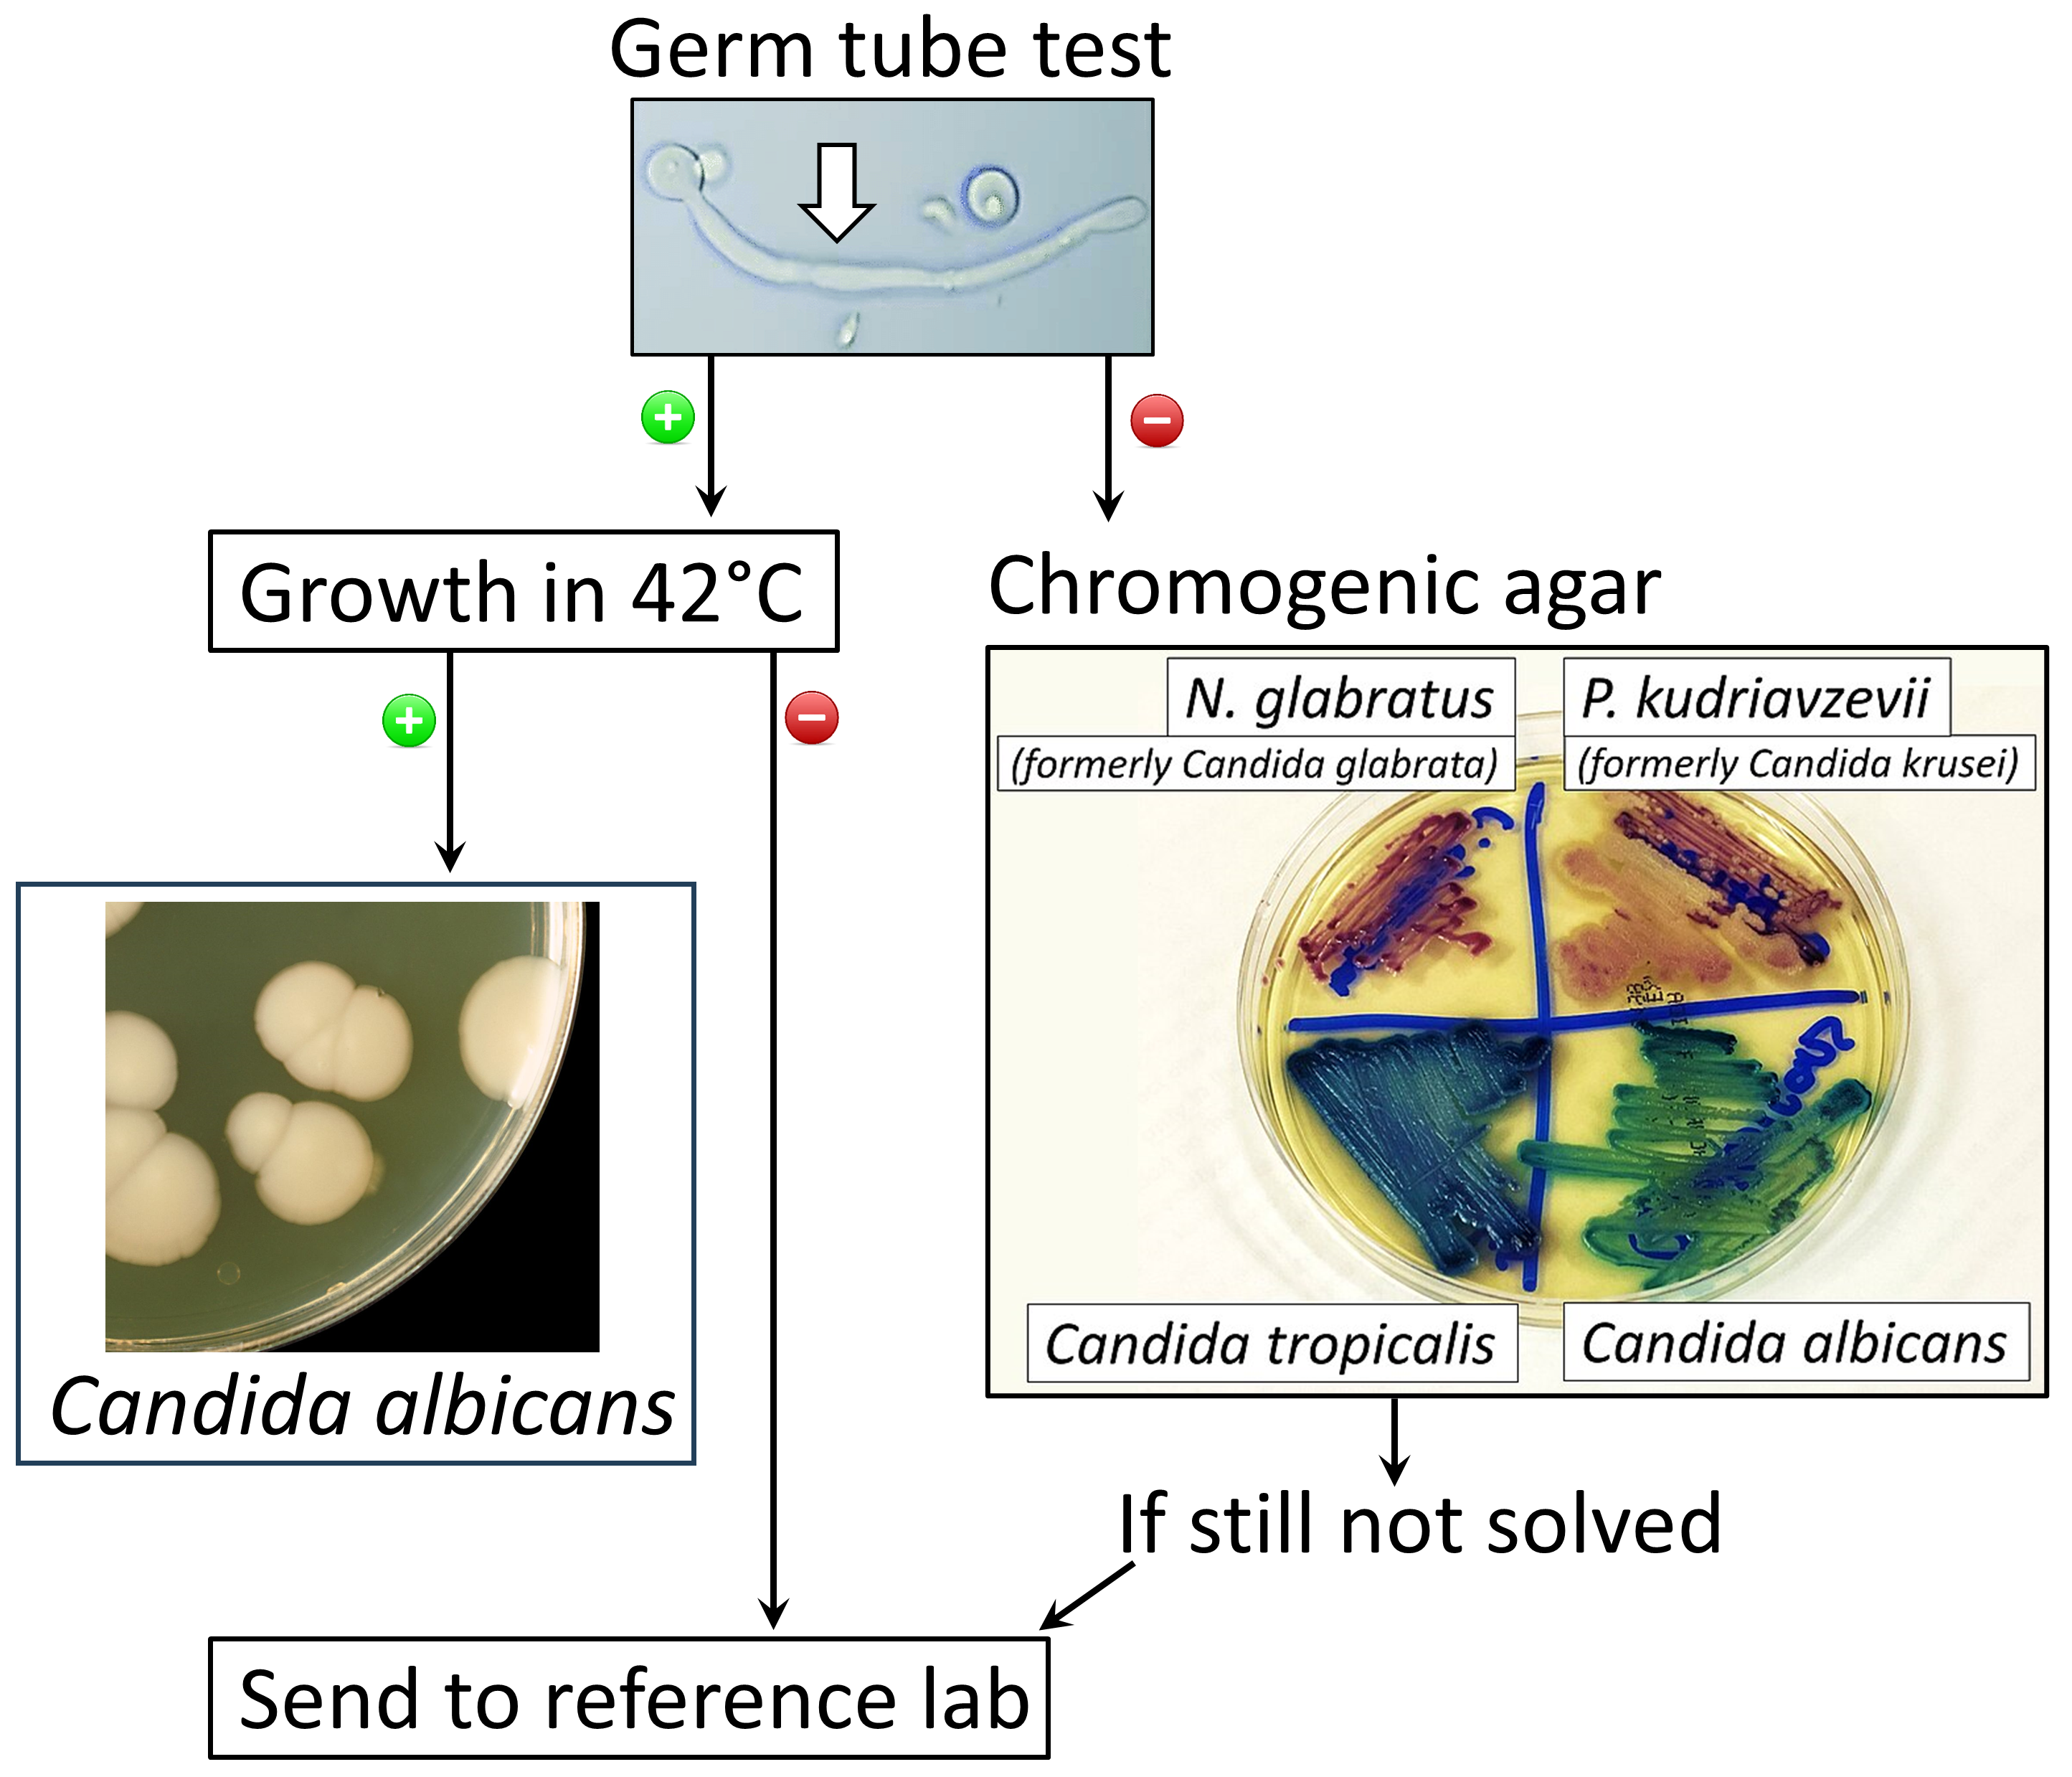

진균증
"오늘의AI위키"의 AI를 통해 더욱 풍부하고 폭넓은 지식 경험을 누리세요.
1. 개요
진균증은 곰팡이에 의해 발생하는 질병으로, 항생제 장기 복용, 면역 저하, 특정 곰팡이 노출 등이 원인이 될 수 있다. 코로나19 유행 동안 일부 진균 감염이 코로나19와 연관되어 나타나기도 했다. 진균증은 표재성, 피하, 전신으로 분류되며, 피부, 폐, 심장 등 다양한 부위에 영향을 미칠 수 있다. 증상은 발진, 덩어리, 폐렴, 수막염 등 다양하게 나타나며, 현미경 검사, 생검, 배양 검사 등을 통해 진단한다. 치료는 항진균제를 사용하며, 수술적 제거가 필요한 경우도 있다. 예방을 위해서는 청결한 위생 관리가 중요하며, 구강 위생 관리도 중요하다.
더 읽어볼만한 페이지
| 진균증 | |
|---|---|
| 일반 정보 | |
| 질병 종류 | 감염병 |
| 진료과 | 감염내과, 피부과 |
| 관련 질병 | 백선, 칸디다증, 아스페르길루스증 |
| 상세 정보 | |
| 동의어 | 진균증 곰팡이병 곰팡이 감염 |
| ICD-10CM 코드 | 진균증 B35-B49 |
| 분야 | 감염병학 |
| 증상 | (정보 없음) |
| 합병증 | (정보 없음) |
| 발병 시기 | (정보 없음) |
| 지속 기간 | (정보 없음) |
| 종류 | 전신성 표재성 피하 |
| 원인 | 병원성 곰팡이: 피부사상균, 효모, 곰팡이 |
| 위험 요인 | 면역 결핍 암 치료 넓은 표면적의 상처/화상 장기 이식 COVID-19 결핵 |
| 진단 | 증상, 배양, 현미경 검사에 기반 |
| 감별 진단 | (정보 없음) |
| 예방 | (정보 없음) |
| 치료 | 항진균제 |
| 약물 | (정보 없음) |
| 예후 | (정보 없음) |
| 빈도 | 흔함 |
| 사망자 수 (2020년) | 170만 명 |
2. 원인
사람들은 강한 항생제를 장기간 복용하면 진균에 감염되기 쉬워지는데, 이는 항생제가 유해한 세균뿐만 아니라 건강에 좋은 세균들도 죽이기 때문이다. 이는 입, 질, 내장 등 신체 내의 미생물 균형을 변화시켜 진균이 지나치게 자라게 만든다.[19]
면역이 약해진 사람들은 진균에 감염될 위험이 높다. HIV/AIDS 환자, 스테로이드를 복용 중이거나 화학요법을 받는 사람들, 당뇨병이 있는 사람도 진균 감염으로 진행되는 경향이 있다.[16][17] 매우 어리거나 나이가 많은 이들도 위험하다.[18]
진균증은 특정 곰팡이에 의해 발생하며, 여기에는 효모, 곰팡이 및 일부 곰팡이 (곰팡이와 효모 모두로 존재 가능)가 포함된다.[3][9] 곰팡이는 어디에나 존재하며, 포자가 흡입되거나 피부에 접촉하거나, 절상, 상처 또는 주사 등을 통해 피부를 통해 신체에 들어간 후 감염이 발생한다.[3] ''칸디다 알비칸스''(칸디다 알비칸스/Candida albicans영어)는 특히 항생제 복용 후 구강 또는 질 칸디다증과 같은 사람의 진균 감염의 가장 흔한 원인이다.[3]
코로나19 범유행 동안 일부 진균 감염이 코로나19와 연관되어 나타났다.[21][22][23] 진균 감염은 코로나19를 모방할 수 있으며, 코로나19와 동시에 발생할 수 있고, 더 심각한 진균 감염은 코로나19의 합병증을 유발할 수 있다.[21] 코로나19 이후 발생한 세균 감염에 대한 항생제 치료 후에 진균 감염이 발생할 수 있다.[24] 코로나19 환자에게서 가장 흔한 심각한 진균 감염으로는 아스페르길루스증 및 침습성 칸디다증이 있다.[25] 코로나19 관련 뮤코르미코시스는 일반적으로 덜 흔하지만, 2021년에는 인도에서 현저히 더 많이 발생한 것으로 나타났다.[21][26]
2. 1. 일반적인 원인
사람들은 강한 항생제를 장기간 복용하면 진균에 감염되기 쉬워지는데, 이는 항생제가 유해한 세균뿐만 아니라 건강에 좋은 세균들도 죽이기 때문이다. 이는 입, 질, 내장 등 신체 내의 미생물 균형을 변화시켜 진균이 지나치게 자라게 만든다.[19]면역이 약해진 사람들은 진균에 감염될 위험이 높다. HIV/AIDS 환자, 스테로이드를 복용 중이거나 화학요법을 받는 사람들, 당뇨병이 있는 사람도 진균 감염으로 진행되는 경향이 있다.[16][17] 매우 어리거나 나이가 많은 이들도 위험하다.[18]
진균증은 특정 곰팡이에 의해 발생하며, 여기에는 효모, 곰팡이 및 일부 곰팡이 (곰팡이와 효모 모두로 존재 가능)가 포함된다.[3][9] 곰팡이는 어디에나 존재하며, 포자가 흡입되거나 피부에 접촉하거나, 절상, 상처 또는 주사 등을 통해 피부를 통해 신체에 들어간 후 감염이 발생한다.[3] ''칸디다 알비칸스''(Candida albicans)는 특히 항생제 복용 후 구강 또는 질 칸디다증과 같은 사람의 진균 감염의 가장 흔한 원인이다.[3]
코로나19 범유행 동안 일부 진균 감염이 코로나19와 연관되어 나타났다.[21][22][23] 진균 감염은 코로나19를 모방할 수 있으며, 코로나19와 동시에 발생할 수 있고, 더 심각한 진균 감염은 코로나19의 합병증을 유발할 수 있다.[21] 코로나19 이후 발생한 세균 감염에 대한 항생제 치료 후에 진균 감염이 발생할 수 있다.[24] 코로나19 환자에게서 가장 흔한 심각한 진균 감염으로는 아스페르길루스증 및 침습성 칸디다증이 있다.[25] 코로나19 관련 뮤코르미코시스는 일반적으로 덜 흔하지만, 2021년에는 인도에서 현저히 더 많이 발생한 것으로 나타났다.[21][26]
2. 2. 한국 특이적인 원인
사람들은 강한 항생제를 장기간 복용하게 되면 진균에 감염되기 쉬워진다. 이는 항생제가 유해한 세균뿐 아니라 건강에 좋은 세균들도 죽이기 때문이다. 이는 입, 질, 내장 등 신체 내의 미생물의 균형을 변화시키며 진균이 지나치게 자라게 만든다.면역이 약해진 사람들은 진균에 감염될 위험이 높다. HIV/AIDS 환자, 스테로이드를 복용 중이거나 화학요법을 받는 사람들이 그러하며, 당뇨병이 있는 사람도 진균 감염으로 진행되는 경향이 있다. 매우 어리거나 나이가 많은 이들도 위험하다.
3. 분류
진균증은 전통적으로 감염이 심하고, 더 광범위하며 내부 신체 기관을 포함하는 표재성, 피하 또는 전신으로 구분된다.[3][14] 진균증은 손발톱, 질, 피부 및 입에 영향을 미칠 수 있다.[15]
진균증은 크게 피부 진균증과 심재성 진균증으로 분류된다.[35] 피부 진균증은 환부가 피부의 각질 등에 머물고 진피에 미치지 않는 표재성 피부 진균증과 환부가 진피 이후의 피하 조직에 미치는 심재성 피부 진균증으로 구분된다.[35]
'''표재성 피부 진균증'''은 주요한 것을 크게 분류하면, 피부사상균증(백선, 족부 백선, 황선, 윤상선), 표재성 칸디다증, 피부 말라세지아증(지루성 습진, 말라세지아 모낭염)이 알려져 있다. 드문 예로 흑선이 있다.[35]
'''심재성 피부 진균증'''은 주요한 것으로, 스포로트리코스증과 크로모미코시스가 있다.[35]
'''심재성 진균증'''은 뇌, 폐, 심장 등 내부 장기까지 미치는 질환으로, 통상 부생균으로서 생활 환경에 상재하거나 숙주에 상재하는 기회 진균증과, 일본에 원래 서식하지 않는 수입 진균증으로 구분된다.[35] 피부과 영역에서 취급하는 전자와 내과계에서 취급하는 후자에서는, 질병의 성질이 크게 다르며, 치료법 및 사용할 수 있는 약제도 다르다.
- '''수입 진균증'''에서는 주요한 것으로, 콕시디오이데스증, 히스토플라스마증, 파라콕시디오이데스증, 말네페이형 페니실리움증, 블라스토미세스증이 있다.[35]
블라스토미코시스, 크립토코쿠스증, 콕시디오이데스 진균증 및 히스토플라스마증과 같은 일부 유형은 세계 특정 지역에 거주하거나 방문하는 사람들에게 영향을 미친다.[15] 아스페르길루스증, 폐포자충 폐렴, 칸디다증, 뮤코르미코시스 및 탈라로마이코시스와 같은 다른 유형은 스스로 감염과 싸울 수 없는 사람들에게 영향을 미치는 경향이 있다.[15]
진균증이 항상 표재성, 피하 및 전신의 세 가지 구분에 엄격하게 부합하는 것은 아닐 수 있다.[3] 일부 표재성 진균 감염은 면역력이 저하된 사람들에게 전신 감염을 유발할 수 있다.[3] 일부 피하 진균 감염은 더 깊은 구조로 침투하여 전신 질환을 유발할 수 있다.[3] ''Candida albicans''는 증상을 나타내지 않고 사람에게 살 수 있으며, 건강한 사람에게 경미한 칸디다증을 유발할 수 있고, 스스로 면역 결핍으로 감염과 싸울 수 없는 사람에게 심각한 침윤성 칸디다증을 유발할 수 있다.[3][10]
3. 1. 표재성 진균증
표재성 진균증에는 건강한 사람의 칸디다증, 피부 백선증(체부 백선, 샅 백선, 수부 백선, 족부 백선, 안면 백선 등), 그리고 어루러기와 같은 ''말라세지아'' 감염이 포함된다.[3][10]
진균증은 피부 진균증과 심재성 진균증으로 크게 분류된다.[35] 피부 진균증은 환부가 피부의 각질 등에 머물고 진피에 미치지 않는 표재성 피부 진균증과 환부가 진피 이후의 피하 조직에 미치는 심재성 피부 진균증으로 구분된다.[35]
표재성 피부 진균증은 주요한 것을 크게 분류하면, 피부사상균증(백선, 족부 백선, 황선, 윤상선), 표재성 칸디다증, 피부 말라세지아증(지루성 습진, 말라세지아 모낭염)이 알려져 있다. 드문 예로 흑선이 있다.[35]
3. 2. 피하 진균증
피하 진균 감염에는 스포로트리코스증, 색소모세포증 및 진균종이 있다.[3]
3. 3. 전신 (심재성) 진균증
전신 진균 감염에는 조직구증, 크립토코쿠스증, 콕시디오이데스증, 블라스토미세스증, 뮤코르증, 아스페르길루스증, 폐포자충 폐렴, 그리고 전신 칸디다증이 포함된다.[3]일차 병원체로 인한 전신 진균증은 일반적으로 폐에서 시작되어 다른 기관계로 퍼질 수 있으며, 전신 진균증을 일으키는 유기체는 본질적으로 독성이 있다. 기회 병원체로 인한 전신 진균증은 AIDS, 항생제에 의한 정상 세균총의 변화, 면역 억제 요법 및 전이성 암과 같은 면역 저하 상태의 환자에게서 발생한다. 기회 진균증의 예로는 칸디다증, 크립토코쿠스증 및 아스페르길루스증이 있다.
심재성 진균증은 뇌, 폐, 심장 등 내부 장기까지 미치는 질환으로, 통상 부생균으로서 생활 환경에 상재하거나 숙주에 상재하는 기회 진균증과, 일본에 원래 서식하지 않는 수입 진균증으로 구분된다.[35] 피부과 영역에서 취급하는 기회 진균증과 내과계에서 취급하는 수입 진균증은 질병의 성질이 크게 다르며, 치료법 및 사용할 수 있는 약제도 다르다.
기회 진균증에서는 주요한 것으로, 칸디다증, 아스페르길루스증, 크립토코쿠스증, 접합균증이 있다.[35]
수입 진균증에서는 주요한 것으로, 콕시디오이데스증, 히스토플라스마증, 파라콕시디오이데스증, 말네페이형 페니실리움증, 블라스토미세스증이 있다.[35]
3. 4. 그 외 (ICD-11 코드 기준)
ICD-11 코드는 다음을 포함한다:[5]- 1F20 아스페르길루스증
- 1F21 바시디오볼루스증
- 1F22 블라스토미코시스
- 1F23 칸디다증
- 1F24 색소모세포진균증
- 1F25 콕시디오이데스진균증
- 1F26 사상균증
- 1F27 크립토코쿠스증
- 1F28 피부사상균증
- 1F29 진균종
- 1F2A 히스토플라스마증
- 1F2B 로보미코시스
- 1F2C 뮤코르증
- 1F2D 비피부사상균 표재성 피부진균증
- 1F2E 파라콕시디오이도미코시스
- 1F2F 파이포히포미코시스
- 1F2G 폐포자충증
- 1F2H 스케도스포리움증
- 1F2J 포도상구균증
- 1F2K 탈라로마이코시스
- 1F2L 에몬스증
진균증은 크게 피부 진균증과 심재성 진균증으로 분류된다.[35] 피부 진균증은 다시 표재성 피부 진균증과 심재성 피부 진균증으로 나뉜다.[35] 표재성 피부 진균증에는 백선, 족부 백선, 황선, 윤상선, 표재성 칸디다증, 지루성 습진, 말라세지아 모낭염 등이 있고, 드물게 흑선이 있다.[35] 심재성 피부 진균증의 주요 예로는 스포로트리코스증과 크로모미코시스가 있다.[35]
심재성 진균증은 뇌, 폐, 심장 등 내부 장기까지 영향을 미치는 질환으로, 기회 진균증과 수입 진균증으로 구분된다.[35] 기회 진균증의 주요 예로는 칸디다증, 아스페르길루스증, 크립토코쿠스증, 접합균증이 있다.[35] 수입 진균증에는 콕시디오이데스증, 히스토플라스마증, 파라콕시디오이데스증, 말네페이형 페니실리움증, 블라스토미세스증 등이 있다.[35]
4. 증상
대부분의 흔한 경증 진균증은 종종 발진으로 나타난다.[2] 피부 또는 피부 아래 감염은 덩어리와 피부 변화로 나타날 수 있다.[3] 덜 흔한 심부 진균 감염은 폐렴과 유사한 증상 또는 수막염으로 나타날 수 있다.[2]
5. 진단
진균증 진단은 일반적으로 징후와 증상, 현미경 검사, 생검, 배양 검사, 때로는 의학 영상의 도움을 통해 이루어진다.[9]
피부의 일부 백선 및 칸디다증 감염은 습진 및 편평 태선과 유사하게 나타날 수 있다.[10] 어루러기는 지루성 피부염, 장미색 비강진, 백색 비강진, 백반증과 유사하게 보일 수 있다.[10]
콕시디오이데스 진균증, 히스토플라스마증, 블라스토미세스증과 같은 일부 진균 감염은 발열, 기침, 호흡 곤란을 동반하여 나타날 수 있으며, 이로 인해 코로나19와 유사할 수 있다.[27]
6. 치료
진균증 치료는 감염 종류에 따라 다르며, 일반적으로 국소 또는 전신 항진균제가 필요하다.[28] 항진균제에 반응하지 않는 폐포자충증은 코트리목사졸로 치료한다.[29] 때로는 감염된 조직을 수술적으로 절제해야 한다.[3]
병인 생물이 원핵생물인 세균일 경우, 치료에는 세균에만 큰 손상을 줄 수 있는 항생 물질을 사용할 수 있다. 이는 인체가 진핵생물이라는 비대칭성이 있기 때문이다.
이에 반해, 진균증은 병인 생물이 인체와 같은 진핵생물로, 다당류로 이루어진 키틴질의 강고한 세포벽을 가지며, 곰팡이 세포에만 손상을 주고 인체 조직에 해가 적은 약물은 매우 제한적이다. 이 때문에 치료가 어려워 완치까지 장기간이 걸린다.
또한, 심재성 진균증은 기회 감염증의 색채가 강하며, 알레르기성 질환이나 아플라톡신 등, 마이코톡신 중독도 보고되고 있다. 증례는 증가 추세에 있으며, 진단에는 곰팡이 배양이나 생검이 필요하지만 발견이 어려운 경우가 많아, 진단 지연으로 치료 개시가 늦어지고, 치사율이 높은 감염증도 발견되고 있다.
진균증에는 항진균제가 사용된다. 진균증의 성질에 따라 국소성 또는 전신성으로 사용된다. 광화학 요법은 균상 식육종의 주요 치료법이다. 이 외에, 전신의 피부, 각질층의 케어, 동시에 구강 내 제균 케어를 습득하여, 그것을 매일 지속하는 것. 오랄 헬스케어, 오랄 케어 트리트먼트에 의한 제균 케어가 기본이 된다.
CHX(0.5% 클로르헥시딘) 액을 수 시간마다 사용함으로써, 곰팡이의 콜로니 활동을 억제할 수 있다. 펀기존 등이나 메트로니다졸의 항진균제와의 병용이 효과가 있다. 콜로니가 체외로 배출되기까지 최소 피부의 턴오버 사이클의 28일 이상 연고, CHX액을 사용하는 것이 권장된다.
7. 예방
피부를 깨끗하고 건조하게 유지하며, 좋은 위생을 유지하는 것은 국소 진균증 예방에 도움이 된다. 다른 사람이나 동물을 만진 후에는 손을 씻고, 운동복은 사용 후 세탁해야 한다. 피부를 청결하고 건조한 상태로 유지하는 것은 건강 상태를 유지하는 것과 마찬가지로 진균증 예방에 효과적이다.
구강 내에는 진균을 포함한 많은 세균군이 존재한다. 치태나 치석이 증가하는 등 구강 위생 관리가 제대로 이루어지지 않으면, 치주 질환균에 감염될 수 있으며, 심재성 진균증(전신성 진균증, 내장 진균증)이 동반될 가능성도 있다. 치주 질환균은 연쇄적으로 고혈압, 동맥 경화, 심장 질환, 뇌 질환, 각 장기 감염 염증, 태아 발육 부전, 불임 등을 유발할 수 있다.
8. 역사
기원전 500년경 히포크라테스가 기록한 구강 궤양은 아구창이었을 가능성이 있다.[33] 1840년대 초, 파리에서 활동하던 헝가리 현미경학자 데이비드 그루비는 곰팡이가 인간 질병을 일으킬 수 있다는 것을 처음으로 보고했다.[33] 2003년 사스 유행 당시, 진균 감염은 사스에 걸린 사람들의 14.8~33%에서 보고되었으며, 사스 환자의 25~73.7%의 사망 원인이었다.[34]
참조
[1]
서적
Weedon's Skin Pathology Essentials
https://books.google[...]
Elsevier
[2]
웹사이트
Fungal Diseases Homepage {{!}} CDC
https://www.cdc.gov/[...]
2021-03-29
[3]
서적
Kumar and Clark's Clinical Medicine
Elsevier
2020
[4]
서적
mycoses B35-B49
https://www.icd10dat[...]
[5]
웹사이트
ICD-11 - ICD-11 for Mortality and Morbidity Statistics
https://icd.who.int/[...]
2021-05-25
[6]
논문
Fungal infections in burns: a comprehensive review
2013-09
[7]
논문
Fungi in the Wound Microbiome
2018-07
[8]
서적
Fungal Infection: Diagnosis and Management
John Wiley & Sons
2012
[9]
서적
Clinically Relevant Mycoses: A Practical Approach
https://books.google[...]
Springer
[10]
서적
Atlas of Clinical Dermatopathology: Infectious and Parasitic Dermatoses
Wiley Blackwell
2021
[11]
논문
Fungal infections in humans: the silent crisis
2020-06
[12]
논문
Neglected endemic mycoses
2017-11
[13]
논문
Fungal infections in animals: a patchwork of different situations
2018-04
[14]
서적
Nanotechnology in Skin, Soft Tissue, and Bone Infections
Springer
2020
[15]
웹사이트
Types of Fungal Diseases {{!}} Fungal Diseases {{!}} CDC
https://www.cdc.gov/[...]
2019-06-27
[16]
웹사이트
Fungal Infections {{!}} Fungal {{!}} CDC
https://www.cdc.gov/[...]
2019-01-29
[17]
웹사이트
Thrush in Men
http://www.nhs.uk/Co[...]
NHS
2013-07-13
[18]
웹사이트
Fungal infections: Introduction
http://www.wrongdiag[...]
2010-05-26
[19]
서적
Acute Care Surgery
https://books.google[...]
Lippincott Williams & Wilkins
2012
[20]
논문
Antifungal therapy in infants and children with proven, probable or suspected invasive fungal infections
2010-02
[21]
웹사이트
Fungal Diseases and COVID-19 {{!}} CDC
https://www.cdc.gov/[...]
2021-06-07
[22]
서적
Fungal Infections Complicating COVID-19
https://books.google[...]
MDPI
2021
[23]
논문
Invasive fungal diseases during COVID-19: We should be prepared
2020-06
[24]
서적
Coronavirus Disease 2019 (COVID-19): Epidemiology, Pathogenesis, Diagnosis, and Therapeutics
https://books.google[...]
Springer
2020
[25]
웹사이트
Fungal Diseases and COVID-19
https://www.cdc.gov/[...]
2021-06-07
[26]
서적
COVID-19: The Essentials of Prevention and Treatment
https://books.google[...]
Elsevier
2021
[27]
웹사이트
Fungal Diseases and COVID-19
https://www.cdc.gov/[...]
2021-06-07
[28]
서적
Clinically Relevant Mycoses: A Practical Approach
https://books.google[...]
Springer
[29]
웹사이트
CDC - DPDx - Pneumocystis
https://www.cdc.gov/[...]
2019-01-22
[30]
논문
Stop neglecting fungi
2017-07
[31]
논문
Trends in Epidemiology and Microbiology of Severe Sepsis and Septic Shock in Children
2020-12
[32]
논문
Fungal diseases as neglected pathogens: A wake-up call to public health officials
2020-02
[33]
서적
Fungal Disease in Britain and the United States 1850-2000: Mycoses and Modernity
https://books.google[...]
Springer
2013-11-11
[34]
논문
Fungal Co-infections Associated with Global COVID-19 Pandemic: A Clinical and Diagnostic Perspective from China
2020-08
[35]
서적
菌類の生物学
共立出版株式会社
[36]
웹사이트
대한의협 의학용어 사전
https://www.kmle.co.[...]
[37]
웹사이트
옛 대한의협 3 의학용어 사전
https://www.kmle.co.[...]
[38]
웹인용
Dorlands Medical Dictionary:mycosis
http://www.mercksour[...]
[39]
웹인용
What Is a Fungal Infection?
http://www.fungalinf[...]
2010-12-31
본 사이트는 AI가 위키백과와 뉴스 기사,정부 간행물,학술 논문등을 바탕으로 정보를 가공하여 제공하는 백과사전형 서비스입니다.
모든 문서는 AI에 의해 자동 생성되며, CC BY-SA 4.0 라이선스에 따라 이용할 수 있습니다.
하지만, 위키백과나 뉴스 기사 자체에 오류, 부정확한 정보, 또는 가짜 뉴스가 포함될 수 있으며, AI는 이러한 내용을 완벽하게 걸러내지 못할 수 있습니다.
따라서 제공되는 정보에 일부 오류나 편향이 있을 수 있으므로, 중요한 정보는 반드시 다른 출처를 통해 교차 검증하시기 바랍니다.
문의하기 : help@durumis.com